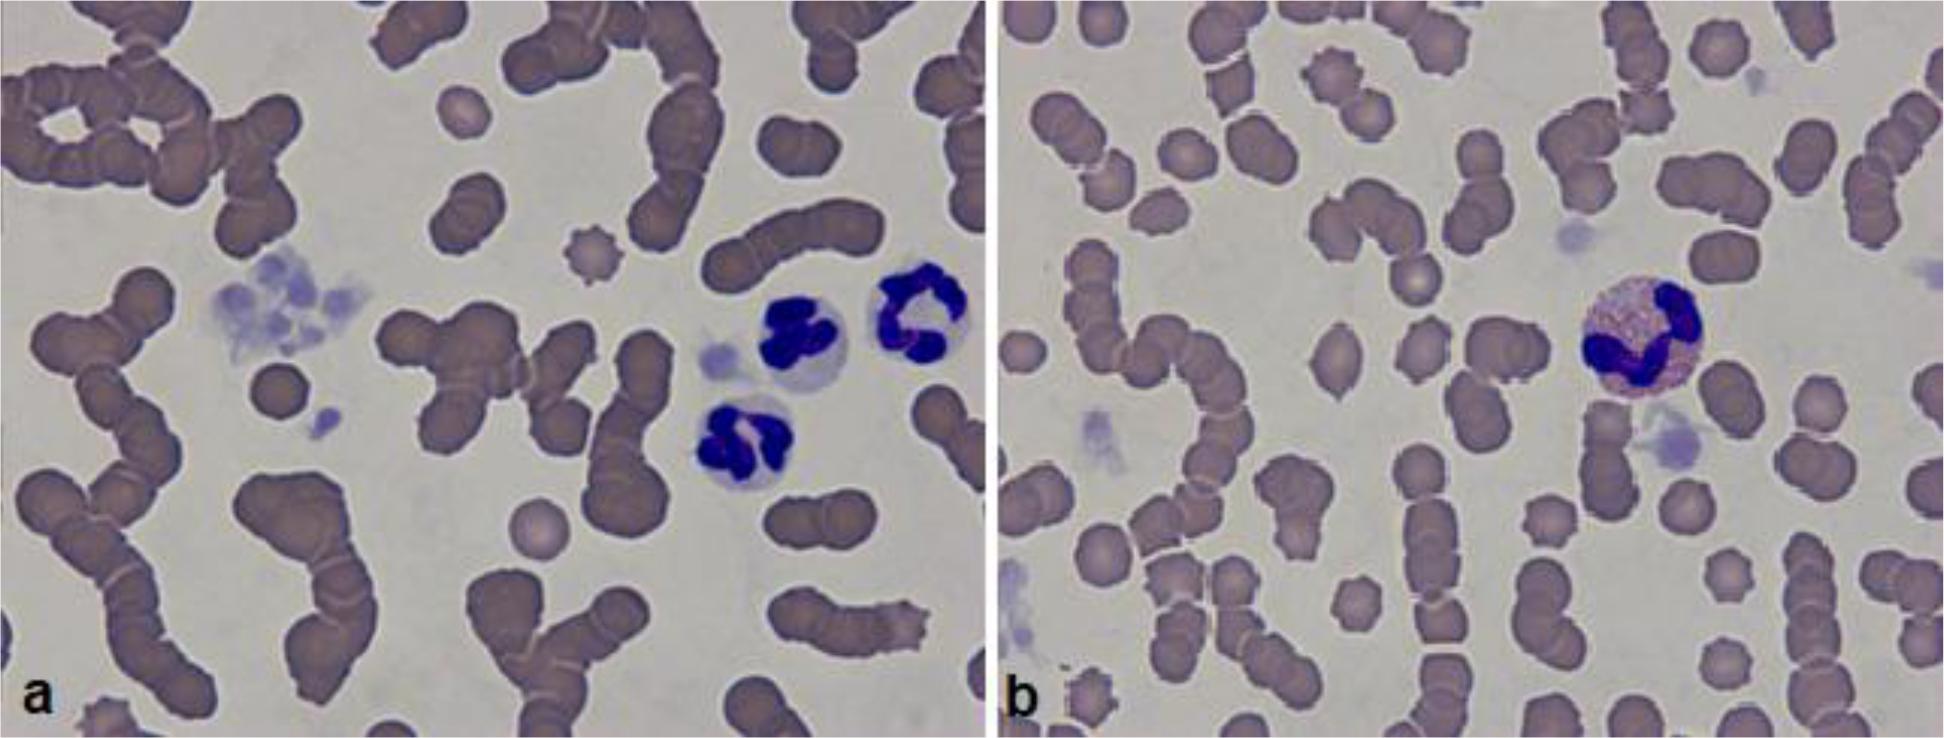

Fig. 1.

Fig. 2.
Fig. 3.

Results of protein electrophoresis, immunoassays, haematological analysis and the comet assay in cats with pathological results
| Electrophoresis (g/L) | FIV | FeLV | FIP | Blood count | Comet assay | Overall condition | |||||||||
|---|---|---|---|---|---|---|---|---|---|---|---|---|---|---|---|
| Alb | α | β | γ | B. c. | WBC | LYM | MON | GRA | Head DNA% | Tail DNA% | |||||
| 1 | 20.06↓ | 20.74↑ | 13.21↑ | 12.99 | 67 | − | + | − | 4.90↓ | 2.5 | 0.1↓ | 2.4 | 64.21 | 35.79 | Good |
| 2 | 33.91 | 14.05↑ | 10.22↑ | 20.82↑ | 79 | − | − | + | 20.40↑ | 4.7↑ | 0.2↓ | 15.5↑ | 78.9 | 21.10 | Good |
| 3 | 41.96↑ | 15.98↑ | 13.21↑ | 30.85↑ | 102↑ | − | − | − | 21.9↑ | 8.5↑ | 2.0↑ | 11.4↑ | 83.22 | 16.78 | Good |
| 4 | 38.76 | 12.90↑ | 6.72 | 21.62↑ | 80 | − | − | − | 14.7 | 4.0↑ | 1.2↑ | 9.6↑ | 83.97 | 16.03 | Good |
| 5 | 37.59 | 19.97↑ | 10.67↑ | 21.77↑ | 90↑ | + | − | − | 2.70↓ | 0.2↓ | 0.0↓ | 2.5 | 79.95 | 20.09 | Upper respiratory infection |
| 6 | 33.75 | 13.66↑ | 10.45↑ | 20.14↑ | 78 | − | − | − | 9.90 | 6.2↑ | 0.3 | 3.5 | 80.37 | 19.63 | Good |
| 7 | 37.49 | 13.38↑ | 9.33↑ | 18.8↑ | 79 | − | − | − | 19.8↑ | 4.0↑ | 1.2↑ | 14.6↑ | 83.11 | 16.89 | Good |
| 8 | 24.45↓ | 15.77↑ | 7.12 | 25.67↑ | 73 | − | − | − | 9.0 | 3.8↑ | 0.9↑ | 4.3 | 70.47 | 29.53 | Good |
| 9 | 26.94↓ | 16.51↑ | 11.57↑ | 28.98↑ | 84↑ | − | − | − | 13.5 | 3.9↑ | 1.2↑ | 8.4↑ | 78.38 | 21.62 | Good |
| 10 | 31.5 | 12.1 | 8.19 | 24.21 ↑ | 76 | − | − | − | 5.60↓ | 1.3 | 0.2↓ | 4.0 | 83.8 | 16.20 | Stomatitis |
| 11 | 28.00 | 12.46↑ | 8.54 | 32.02↑ | 81↑ | − | − | + | 5.60↓ | 2.0 | 0.5 | 3.1 | 68.08 | 31.92 | Good |
| 12 | 33.15 | 12.79↑ | 10.63↑ | 25.43↑ | 82↑ | − | − | − | 30.8↑ | 8.3↑ | 1.5↑ | 20.9↑ | 78.54 | 21.46 | Good |
| 13 | 28.12 | 10.11 | 9.05↑ | 38.72↑ | 86↑ | − | − | − | 21.6↑ | 4.8↑ | 1.5↑ | 15.3↑ | 78.93 | 21.07 | Upper respiratory infection |
| 14 | 34.52 | 13.25↑ | 9.61 ↑ | 24.62↑ | 82↑ | − | − | − | 18.9↑ | 7.0↑ | 1.7↑ | 10.2↑ | 79.43 | 20.57 | Good |
| 15 | 31.41 | 13.52↑ | 9.84↑ | 23.23↑ | 78 | − | − | − | 12.6 | 3.8↑ | 1.3↑ | 7.6↑ | 79.92 | 20.08 | Good |
| 16 | 33.10 | 16.18↑ | 11.69↑ | 9.03↓ | 70 | − | − | − | 9.1 | 3.5↑ | 0.6 | 5.0 | 80.45 | 19.55 | Good |
| 17 | 32.6 | 11.72 | 10.58↑ | 23.1↑ | 78 | − | − | − | 8.9 | 1.6 | 0.5 | 6.8 | 82.47 | 17.53 | Good |
| 18 | 27.02 | 12.58↑ | 7.19 | 49.21 ↑ | 96↑ | − | − | − | 19.2 | 6.7↑ | 1.3↑ | 11.1↑ | 78.38 | 21.62 | Upper respiratory infection |
| 19 | 35.25 | 8.25 | 7.66 | 20.85↑ | 72 | − | − | − | 8.5 | 2.1 | 0.8 | 5.6 | 80.7 | 19.30 | Good |
| 20 | 24.78↓ | 13.55↑ | 10.34↑ | 12.33 | 61 | − | − | − | 7.1 | 2.0 | 0.6 | 4.5 | 82.78 | 17.22 | Good |
| 21 | 24.53↓ | 10.71 | 6.84 | 17.93 | 70 | − | + | − | 17.7 | 2.7 | 1.2↑ | 13.8↑ | 65.07 | 34.93 | Good |
| 22 | 26.12↓ | 12.65↑ | 10.55↑ | 26.68↑ | 76 | − | − | − | 6.7 | 2.0 | 0.5 | 4.2 | 72.36 | 27.64 | Good |
| 23 | 18.20↓ | 11.64 | 5.96 | 18.20 | 54↓ | + | − | − | 15.30 | 4.0↑ | 0.8 | 10.6↑ | 64.21 | 35.79 | Good |
| 24 | 25.79↓ | 15.69↑ | 8.23 | 12.29 | 62 | − | − | − | 6.70 | 2.0 | 0.5 | 4.2 | 67.23 | 32.77 | Upper respiratory infection |
| 25 | 26.05↓ | 14.42↑ | 9.57↑ | 20.96↑ | 71 | − | − | − | 8.50 | 2.9 | 0.2↓ | 5.4 | 67.00 | 33.00 | Upper respiratory infection |
Concentrations of individual protein fractions in serum protein electrophoresis – cat No_ 1
| Fraction | Relative area (%) | Concentration (g/L) | Range (g/L) | Albumin-to-globulin ratio |
|---|---|---|---|---|
| Albumins | 29.93 | 20.06↓ | 27–39 | |
| α-globulins | 30.96 | 20.74↑ | 6.5–12.1 | |
| β-globulins | 19.72 | 13.21↑ | 4.5–8.7 | |
| γ-globulins | 19.39 | 12.99 | 10.0–18.6 | |
| Total protein | 67 | 60–80 | ||
| A/G ratio | 0.43 |
Means for Head DNA% and Tail DNA% in comet assays on lysed whole blood of cats with impaired DNA integrity
| Cat | Head DNA% | Tail DNA% | ||
|---|---|---|---|---|
| Mean | Standard deviation | Mean | Standard deviation | |
| 1 | 64.21b | 29.10 | 35.79a | 29.10 |
| 2 | 78.90ba | 21.45 | 21.10ba | 21.45 |
| 3 | 83.22a | 14.34 | 16.78b | 14.34 |
| 4 | 83.97a | 17.57 | 16.03b | 17.57 |
| 5 | 79.95ba | 17.56 | 20.09ba | 17.56 |
| 6 | 80.37ba | 18.87 | 19.63ba | 18.87 |
| 7 | 83.11a | 15.90 | 16.89b | 15.90 |
| 8 | 70.47ba | 25.54 | 29.53ba | 25.54 |
| 9 | 78.38ba | 17.23 | 21.62ba | 17.23 |
| 10 | 83.80a | 15.41 | 16.20b | 15.41 |
| 11 | 68.08ba | 32.72 | 31.92ba | 32.72 |
| 12 | 78.54ba | 17.39 | 21.46ba | 17.39 |
| 13 | 78.93ba | 17.47 | 21.07ba | 17.47 |
| 14 | 79.43ba | 17.59 | 20.57ba | 17.59 |
| 15 | 79.92ba | 17.54 | 20.08ba | 17.54 |
| 16 | 80.45ba | 17.56 | 19.55ba | 17.56 |
| 17 | 82.47a | 18.25 | 17.53b | 18.25 |
| 18 | 78.38ba | 17.23 | 21.62ba | 17.23 |
| 19 | 80.70ba | 17.79 | 19.30ba | 17.79 |
| 20 | 82.78a | 18.44 | 17.22b | 18.44 |
| 21 | 65.07b | 29.93 | 34.93a | 29.93 |
| 22 | 72.36ba | 30.58 | 27.64ba | 30.58 |
| 23 | 64.21b | 29.10 | 35.79a | 29.10 |
| 24 | 67.23ba | 31.09 | 32.77ba | 31.09 |
| 25 | 67.00ba | 30.53 | 33.00ba | 30.53 |
| Total | 76.48 | 21.45 | 23.52 | 21.45 |
Means for Head DNA% and Tail DNA% in comet assays on lysed whole blood of cats with normal DNA integrity
| Cat | Head DNA% | Tail DNA% | ||
|---|---|---|---|---|
| Mean | Standard deviation | Mean | Standard deviation | |
| 1 | 99.44ba | 1.56 | 0.56ba | 1.56 |
| 2 | 99.92a | 0.19 | 0.08b | 0.19 |
| 3 | 99.29ba | 2.22 | 0.71ba | 2.22 |
| 4 | 98.29b | 4.17 | 1.71a | 4.17 |
| 5 | 99.59ba | 0.72 | 0.41ba | 0.72 |
| 6 | 99.70a | 0.61 | 0.30b | 0.61 |
| 7 | 99.65a | 0.64 | 0.35b | 0.64 |
| 8 | 99.24ba | 2.35 | 0.76ba | 2.35 |
| 9 | 99.93a | 0.25 | 0.07b | 0.25 |
| 10 | 99.91a | 0.18 | 0.09b | 0.18 |
| 11 | 99.76a | 0.45 | 0.24b | 0.45 |
| 12 | 99.79a | 0.30 | 0.21b | 0.30 |
| 13 | 99.95a | 0.16 | 0.05b | 0.16 |
| 14 | 99.61a | 1.96 | 0.39b | 1.96 |
| 15 | 99.98a | 0.09 | 0.02b | 0.09 |
| 16 | 99.94a | 0.16 | 0.06b | 0.16 |
| 17 | 99.75a | 1.09 | 0.25b | 1.09 |
| 18 | 98.95ba | 5.78 | 1.05ba | 5.78 |
| 19 | 98.91ba | 3.18 | 1.09ba | 3.18 |
| 20 | 99.43ba | 1.74 | 0.57ba | 1.74 |
| 21 | 99.93a | 0.12 | 0.07b | 0.12 |
| 22 | 99.96a | 0.13 | 0.04b | 0.13 |
| 23 | 99.96a | 0.14 | 0.04b | 0.14 |
| 24 | 99.98a | 0.08 | 0.02b | 0.08 |
| 25 | 99.83a | 0.28 | 0.17b | 0.28 |
| Total | 99.63 | 1.14 | 0.37 | 1.14 |
Comet assay results on lysed whole blood – cat No_ 1
| Head DNA (%) | Tail DNA (%) | ||
|---|---|---|---|
| Mean | Standard deviation | Mean | Standard deviation |
| 64.21 | 29.10 | 35.79 | 29.10 |
Haematological analysis – cat No_ 1
| Parameter | Result | Reference |
|---|---|---|
| WBC | 4.90↓ | 6.0–18.0×103/mm3 |
| RBC | 3.31↓ | 6.5–10.0×106/mm3 |
| HGB | 3.40↓ | 6.2–9.3 mmol/L |
| HCT | 0.15↓ | 0.30–0.45 |
| MCV | 46 | 39–55 μm3 |
| MCHC | 22.3 | 18.6–22.3 mmol/L |
| PLT | 230 | 200–600×103/mm3 |
| %LYM | 50 | 20–55 % |
| %MON | 2 | 1–10 % |
| %GRA | 48 | 35–75 % |
| LYM | 2.5 | 1.2–3.2×103/mm3 |
| MON | 0.1↓ | 0.3–0.8×103/mm3 |
| GRA | 2.4 | 1.2–6.8×103/mm3 |
Values of Student’s t-test of the differences between DNA in cats with impaired and normal DNA integrity evaluated using the comet assay
| Health status | Head DNA (%) | Tail DNA (%) | ||||
|---|---|---|---|---|---|---|
| Mean | t-test value | P-value | Mean | t-test value | P-value | |
| Cats with normal DNA integrity | 99.62 | 16.91 | 0.000 | 0.37 | 17.01 | 0.000 |
| Cats with impaired DNA integrity | 76.48 | 23.52 | ||||